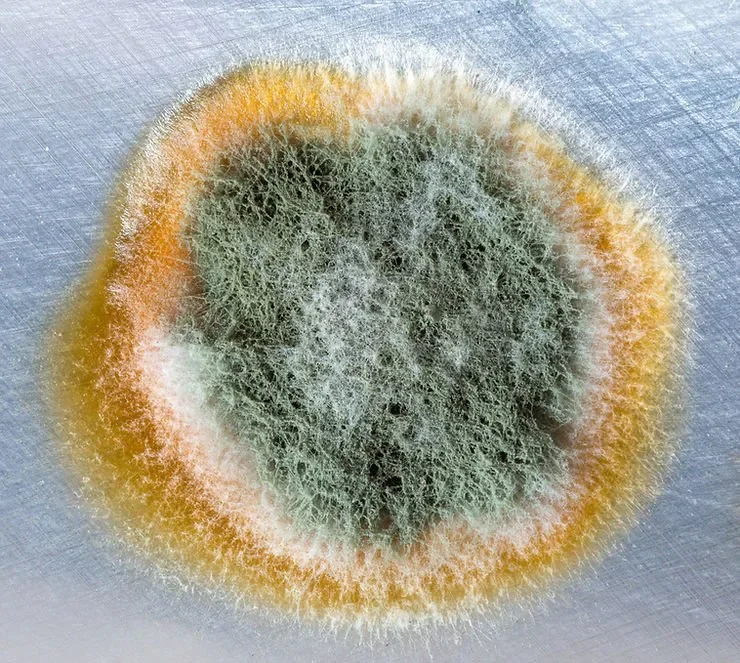

Mold and mildew are a natural part of our environment and can be found growing just about everywhere—even in our bathrooms. If you find dark spots on the walls or discoloration in your bathroom tiles, you might wonder, “How do I know if I have mold or mildew in my bathroom? Are they dangerous? What’s the difference?”
How do I know if it’s mold or mildew?
Simply put, mildew is another name for mold. According to the Environmental Protection Agency (EPA), mildew is a type of mold or fungus and generically refers to mold growth. Mildew is a specific type of mold that shows up in damp areas like bathroom walls, ceilings, window sills, and shower stalls.
Mildew loves warmth and humidity. It thrives most when the relative humidity is between 62 and 93 percent, and the ambient temperature falls between 77ºF and 88ºF. Mildew is a surface fungus that usually looks white or grey. It also appears dry or powdery and flat so it’s easier to spot in those damp areas.
Mold, by contrast, appears raised and slimy or fuzzy. It also comes in a variety of colors such as green, red, blue, and black. There are several species of mold, all of which can grow in fibrous materials like wood, paper, and carpet, or on porous surfaces like concrete. Some molds will even grow on the backside of toilets and under bathroom sinks.
Unlike mildew, mold is not limited to surface areas. It can get underneath surfaces and inside of walls, crawl spaces, and air ducts, making it harder to detect. Another difference between mold and mildew is the smell. Mildew has a mild, musty smell, while mold has a stronger, more powerful odor because of the microbial volatile organic compounds (MVOCs) it produces.
How does mold exposure affect my health?
Indoor mold and mildew have a big impact on overall air quality. Mold and mildew exposure can cause cold-like symptoms such as sore throats, headaches, and mild respiratory problems. Mold exposure may also worsen allergies, asthma, or breathing issues in people with preexisting lung conditions.
There are health risks associated with any exposure to mold and mildew. However, the greatest risks come from exposure to black mold (Stachybotrys chartarum), Chaetomium and Penicillium/aspergillus.
Exposure to black mold has been linked to insomnia, anxiety, depression, confusion, and trouble concentrating. It can also cause itchy skin, skin rashes, eye irritation, congestion, mood changes, and depression.
Don’t Leave Your Health to Chance
If you suspect you have mold in your bathroom, contact My Pure Environment SF for a consultation. We have trained technicians standing by. We’ll take an air quality sample and determine how best to treat your mold problem. Our mold remediation methods at My Pure Environment SF are fast, effective, and non-invasive. Give us a call at (415) 570-1711 for safe, quick, and effective mold remediation in San Francisco, California.
Photo by Sidekix Media on Unsplash (11/9/2021)